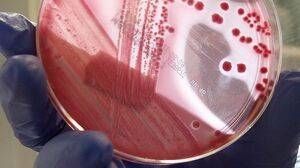
Cazul bebeluşilor infectaţi cu bacteria ucigaşă nu e singular. În Germania,criza a ucis 53 de oameni

Cazul bebeluşilor infectaţi cu bacteria ucigaşă nu e singular. În Germania,criza a ucis 53 de oameni
Cazul bebeluşilor infectaţi cu bacteria ucigaşă nu e singular. În Germania,criza a ucis 53 de oameni
Cazul bebeluşilor internaţi în spitalele din Bucureşti, infectaţi cu o bacterie care a ucis deja doi dintre ei, este similar cu o criză medicală care a avut loc în 2011, în Germania.
Autorităţile sanitare germane s-au confruntat cu mii de îmbolnăviri provocate de bacteria E.coli, relata la acea vreme Reuters. Criza a izbucnit în nordul Germaniei, în luna mai 2011, iar de atunci până la finalul lui iunie aproape 4.000 de oameni au fost diagnosticaţi cu sindrom hemolitic uremic - care provoacă diaree şi probleme renale extrem de grave. Dintre bolnavi, 53 au murit, arată Science Daily, conform Ziare.com.
De aceeaşi afecţiune suferă şi bebeluşii internaţi în ţară noastră la Spitalul "Marie Curie" din Capitală, unde până acum au murit doi copii.
Valul de îmbolnăviri de la noi a început în urmă cu circa trei săptămâni în judeţul Argeş, iar de atunci s-a extins şi în alte judeţe. Iniţial, 14 copii au ajuns în stare gravă la spitalele din Capitală. În prezent, patru bebeluşi sunt internaţi la terapie intensivă la "Marie Curie", dintre care doi sunt intubaţi, iar pe dializă peritoneală mai sunt trei pacienţi.
Deosebirea este că autorităţile române nu au putut confirma până acum dacă îmbolnăvirea a fost provocată de bacteria E.coli. Mai mult, nu s-a descoperit încă nici sursă contaminării. În urmă controalelor s-a stabilit că nu sunt de vină nici apa plată, nici laptele praf, nici portocalele pe care le-ar fi consumat micuţii.
Şi oficialii germani au avut de furcă, în 2011, cu depistarea sursei din cauza căreia zeci de oameni au murit, iar mii au ajuns la spital cu complicaţii grave. Iniţial, experţii sanitari au dat vina în mod greşit pe castraveţii importaţi din Spania, însă ulterior au recunoscut că nu din serele spaniole a provenit intoxicaţia, întrucât în mostrele de legume nu s-a găsit bacteria E.coli, a scris BBC.
Abia pe 30 iunie, autorităţile germane au arătat că o fermă din Bienenbuttel, Saxonia Inferioară, este sursă infecţiilor, potrivit BBC.
Mai exact, Ministerul Agriculturii din Germania a anunţat că seminţele unei plante, folosite pe post de condiment, au infectat mii de oameni cu bacteria mortală E.coli. Este vorba despre plantă Schinduful, denumită şi fan grecesc, pe care ferma o importa din Egipt.
Rămâne de văzut dacă autorităţile de la noi vor identifica sursă îmbolnăvirii celor 14 copii, în condiţiile în care momentan nu au nicio pistă.
Citește și:
- 19:37 - Reacția MAE, după ce a fost convocat la sediu Ambasadorul Federației Ruse la București
- 19:05 - Dan Dungaciu, verdictul momentului: „Hai să facem anticipate și vom avea o Românie guvernată stabil”
- 18:54 - Amenzi uriașe pentru șoferii care merg pe banda de autobuz. Haos total în traficul din Capitală, polițiștii intervin urgent
- 18:41 - Dan Dungaciu, dezvăluiri din interiorul crizei politice: „Au existat discuții ale membrilor AUR cu PSD-PNL-USR. Așteptăm moțiunea”
Mai multe articole despre
Urmărește știrile Realitatea.NET și pe Google News













